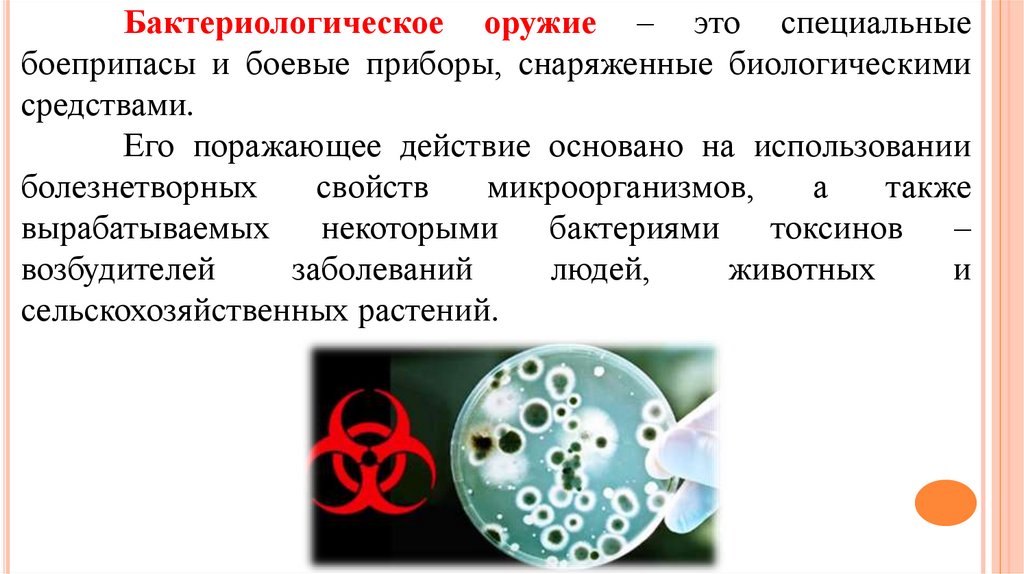

Похожие презентации:
Оружие массового поражения и его поражающие факторы
1.
Оружие массового поражения и егопоражающие факторы
2.
Оружие массового поражения (ОМП) –средство ведения войны, обладающее большой
поражающей способностью.
Ядерное Химическое Бактериологическое
3.
Ядерное оружие и егобоевые свойства
4.
6 и 9 августа 1945 года американцы провелипервую в истории атомную бомбардировку. Жертвами
смертоносного оружия стали японские города
Хиросима и Нагасаки.
5.
Ядерное оружие – вид оружиямассового
поражения
взрывного
действия, основанное на использовании
внутриядерной энергии.
Ядерный взрыв
– взрыв,
вызванный быстрым освобождением
большого количества ядерной энергии.
6.
Ядерные взрывыВоздушные
Наземные (надводные)
Подземные
(подводные)
7.
Радиоактивное заражение местности привоздушном ядерном взрыве практически отсутствует.
Радиус поражения наземного ядерного взрыва
на 20% меньше воздушного. Характерная особенность
наземного взрыва – сильное радиоактивное заражение
местности в районе взрыва и по следу движения
радиоактивного облака.
8.
Основной поражающий фактор –волна сжатия, распространяющаяся в
грунте или воде.
Подводный ядерный взрыв
9.
Центр – точка, в которой произошелвзрыв.
Эпицентр ядерного взрыва –
проекция на земную или водную
поверхность точки центра ядерного
взрыва.
10.
Поражающие факторыядерного взрыва
11.
Ударная волна – один из основных поражающихфакторов ядерного взрыва, так как большинство разрушений и
повреждений сооружений, зданий, а также поражений людей
обусловлены ее воздействием.
В зависимости от характера разрушений в очаге ядерного
поражения выделяют 4 зоны: полных, сильных, средних и
слабых разрушений.
12.
Световое излучение – поток лучистой энергии, включающийультрафиолетовые, видимые и инфракрасные лучи.
Источник – светящаяся область, образуемая раскаленными
продуктами взрыва и раскаленным воздухом.
Распространяется практически мгновенно и длится в зависимости
от мощности ядерного взрыва до 20с.
Способно вызывать ожоги кожи, поражение (постоянное или
временное) органов зрения людей и возгорание горючих материалов и
объектов.
Защита – предметы, создающие тень.
13.
Проникающаярадиация
–
ионизирующее излучение в виде потока гаммалучей и нейтронов.
Время действия на наземные объекты –
15-25с.
Оно определяется временем подъема
облака взрыва на такую высоту (2-3км), при
которой
гамма-нейтронное
излучение,
поглощаясь толщей воздуха, практически не
достигает поверхности земли.
14.
15.
Радиоактивное загрязнениеИсточники – продукты деления ядерного заряда и
радиоактивные изотопы, образующиеся в результате
воздействия нейтронов на материалы, из которых изготовлен
ядерный боеприпас, и на некоторые элементы, входящие в
состав грунта в районе взрыва.
Радиоактивные частицы, выпадая из облака на землю,
образуют зону радиоактивного загрязнения (след), длина
которой может достигать нескольких сотен километров.
16.
УмеренноеОпасное
Зоны загрязнения:
Сильное
Чрезвычайно опасное
17.
Электромагнитныйимпульс
–
кратковременное
электромагнитное
поле,
возникающее при взрыве ядерного боеприпаса
в результате взаимодействия испускаемых при
этом гамма-лучей и нейтронов с атомами
окружающей среды.
18.
Бактериологическое оружие19.
Бактериологическое оружие – это специальныебоеприпасы и боевые приборы, снаряженные биологическими
средствами.
Его поражающее действие основано на использовании
болезнетворных
свойств
микроорганизмов,
а
также
вырабатываемых некоторыми бактериями токсинов –
возбудителей
заболеваний
людей,
животных
и
сельскохозяйственных растений.
20.
Что такое бактерии, вирусы, риккетсии, грибки?Бактерии
—
одноклеточные
микроорганизмы
растительной природы, весьма чувствительные к воздействию
высокой температуры, солнечного света, дезинфицирующих
средств.
Вирусы — группа микроорганизмов, способных жить и
размножаться только в живых клетках (внутриклеточные
паразиты).
Риккетсии — группа микроорганизмов, занимающая
промежуточное положение между бактериями и вирусами.
Грибки — одно- или многоклеточные микроорганизмы
растительного происхождения. Они могут образовывать споры,
обладающие высокой устойчивостью к замораживанию,
высушиванию, действию солнечных лучей.
21.
Когда было впервые использованобактериологическое оружие?
Первое применение бактериологического
оружия произошло в 1346 году во время
осады крымского города Каффа (нынешняя
Феодосия).
22.
Оно предназначено для массового поражения людей,сельскохозяйственных
животных
и
посевов
сельскохозяйственных культур.
Оказывает поражающее воздействие в течение длительного
времени.
Имеет скрытый период, определяется с помощью
лабораторных исследований. Микробы и токсины трудно
обнаруживаются во внешней среде, могут проникать вместе с
воздухом в негерметичные укрытия и помещения и вызывать
заболевания людей и животных.
23.
Каким образом можно применятьбактериологическое оружие?
Аэрозольный — заражение приземного слоя воздуха
частицами аэрозоля путем распыления биологических рецептур
при помощи распылительных средств и взрывов;
трансмиссивный — рассеивание искусственно зараженных
кровососущих переносчиков болезней, которые затем через
укусы передают людям и животным возбудителей опасных для
них заболеваний;
диверсионный — заражение биологическими средствами
воздуха и воды в замкнутых пространствах при помощи
диверсионного снаряжения.
24.
Признаки применяемого бактериологического (биологического) оружия:- глухой, в отличие от взрыва обычных боеприпасов, звук разрыва снарядов и
бомб;
- наличие в местах разрывов крупных осколков и отдельных частей
боеприпасов;
- появление капель жидкости или порошкообразных веществ на местности;
- необычное скопление насекомых и клещей в местах разрыва боеприпасов и
падения контейнеров;
- массовые заболевания людей и животных.
25.
При обнаружении признаков применения данного оружиянемедленно надевают противогазы (респираторы, маски), а также средства
защиты кожи. Очагом бактериологического поражения считаются
населенные пункты и объекты хозяйства, подвергшиеся воздействию
бактериальных
средств,
создающих
источник
распространения
инфекционных заболеваний. Вокруг очага устанавливают вооруженную
охрану, запрещают въезд и выезд, а также вывоз имущества.
Для предотвращения распространения инфекционных заболеваний
проводится комплекс противоэпидемических и санитарно-гигиенических
мероприятий: экстренная профилактика; обсервация и карантин; санитарная
обработка населения; дезинфекция различных зараженных объектов. При
необходимости уничтожают насекомых, клещей и грызунов (дезинсекция и
дератизация).

Военное дело
Военное дело








